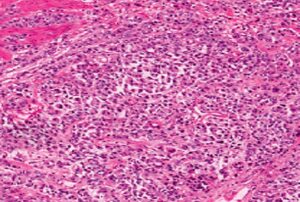
Рак желудка

Желудок находится в верхней части брюшной полости. Он играет важнейшую роль в пищеварении. После проглатывания пища проходит вниз по мышечной трубке (пищевод), соединяющей горло с желудком. При попадании в желудок пища смешивается – вырабатывается желудочный сок, способствующий ее измельчению. Затем пищевой комок перемещается в тонкий кишечник для дальнейшего переваривания.
Рак желудка начинается, когда здоровые клетки ткани изменяются и неконтролируемо растут. Следует различать раковую и доброкачественную опухоли. Раковая (злокачественная) может разрастаться, захватывая соседние органы и системы. Доброкачественная – растёт, но не переходит на другие ткани.
Основная форма онкопроцесса желудка – аденокарцинома. Это означает, что новообразование развилось в железистой ткани, выстилающей внутреннюю часть желудка. Другие виды раковых опухолей включают в себя лимфому, карциному желудка и нейроэндокринную опухоль, но они возникают редко.
Стадия определяет расположение опухоли, ее распространенность, а также ее влияние на организм в целом. Врачам может потребоваться информация, основанная на образцах ткани, полученных при операции, поэтому определение стадии обычно продолжается до проведения всех анализов. Эта информация помогает врачу определить, какое лечение является оптимальным, спрогнозировать возможность выздоровления.
Для определения стадии рака каждого пациента результаты объединяются. Выделяют 5 стадий: стадия 0 (ноль), которая представляет собой неинвазивную протоковую карциному in situ (ПКИС), и стадии с I по IV (с 1 по 4).
Разберем подробно каждый элемент системы TNM для рака желудка:
В системе TNM буква T плюс буква или цифра (от 0 до 4) используются для описания того, насколько далеко опухоль проросла. Размер образования измеряется в сантиметрах (см).
Стадии также делятся на более мелкие подгруппы, помогающие еще подробнее охарактеризовать опухоль.
N в системе TNM означает лимфатические узлы. Это маленькие органы в форме фасолины, помогают противостоять инфекциям. Лимфоузлы в брюшной полости называются регионарными, а в других органах – отдаленными лимфоузлами. Общий прогноз для пациентов с онкологией основан на том, сколько регионарных лимфоузлов имеют патологические признаки.
Буква M в системе TNM означает разрастание опухоли в другие (часто соседние) органы. Это называют отдаленными метастазами.
Врачи устанавливают стадию рака, комбинируя классификации T, N и M.
Стадия 0: Также называется карцинома in situ. Опухоль расположена только на поверхности эпителия, не прорастая в другие слои желудка. Это считается онкопроцессом на начальной стадии (Tis, N0, M0).
Стадия IA: Рак пророс во внутренние слои стенки желудка, не распространяясь на лимфоузлы и другие органы (T1, N0, M0).
Стадия IB: Рак желудка относится к стадии IB при выполнении одного из 2 условий:
Стадия IIA: Рак желудка относится к стадии IIA при выполнении одного из условий:
Стадия IIB: Рак желудка относится к стадии IIB при выполнении одного из следующих условий:
Стадия IIIA: Рак желудка относится к стадии IIIA при выполнении одного из следующих условий:
Стадия IIIB: Рак желудка относится к стадии IIIB при выполнении одного из следующих условий:
Стадия IIIC: Рак желудка относится к стадии IIIC при выполнении одного из следующих условий:
Стадия IV: IV стадия рака желудка описывает рак любого размера, который распространился в отдаленные части тела, помимо области вокруг желудка (любые T, любые N, M1).
Рецидив рака – это возвращение онкологии после лечения. Локальный (регионарный) рецидив повторно проявляется в том же месте. Могут образовываться и отдаленные метастазы. В случае рецидива потребуется снова сдать все анализы для определения его степени.
В Японии существует другой метод определения стадии рака желудка, основанный на расположении вокруг желудка лимфатических узлов, содержащих раковые клетки. Хирургическое вмешательство при раке желудка можно характеризовать с использованием японской системы. Тип операции определяется тем, какие лимфоузлы удалены помимо желудка.
Информация о стадии рака поможет врачу порекомендовать специальный план лечения.

Онкология не обнаруживается на ранней стадии, так как не вызывает никаких специфических симптомов. Ниже приведены симптомы рака желудка.
К симптомокомплексу распространенного рака относятся:
Важно помнить, что жалобы также могут быть вызваны многими другими заболеваниями, в частности, желудочным вирусом или язвой.
«Стандарт оказания медицинской помощи» означает лучшие из известных методов лечения. В качестве онкопомощи рекомендуются также клинические исследования. Они помогают проверять новый подход к лечению. Врачи хотят узнать, является ли это лечение безопасным, эффективным и, возможно, более приемлемым, чем стандартное. Клинические исследования могут проверять лекарственную новинку, комбинацию проверенных методик или вариации дозировок стандартных препаратов или других методов лечения. Клинические исследования являются вариантом онкопомощи на каждой стадии процесса. Ваш врач может помочь вам рассмотреть все варианты терапии.
Междисциплинарная команда составляет общий план лечения. При раке желудка в такие команды могут входить следующие врачи:

Лечение рака желудка состоит из хирургического вмешательства, радиотерапии, химиотерапии, таргетной терапии или иммунотерапии. Варианты лечения и рекомендации зависят от нескольких факторов, включая тип и стадию рака, возможные негативные реакции организма, личные предпочтения, наличие хронической патологии. Для лечения онкологии чаще всего рекомендуется комбинация разных методик. Лечение опухоли может усложняться в связи с тем, что ее часто обнаруживают только на последних стадиях.
Уделите время изучению всех вариантов лечения и обязательно задайте вопросы обо всем, что непонятно. Обсудите с врачом цель каждого вида терапии и что вам следует ожидать во время лечения. Такие беседы называются «совместным принятием решения».
Это устранение новообразования прилегающей здоровой ткани с помощью оперативного вмешательства. Вид операции зависит от стадии онкопроцесса.
При раке на очень ранней стадии (T1a) некоторые врачи могут порекомендовать нехирургическое лечение, называемое эндоскопической резекцией слизистой оболочки. При начальных стадиях (стадии 0 или I), когда рак еще находится только в желудке, хирургическое вмешательство используется для иссечения части желудка, содержащей рак, и соседних лимфоузлов. Это называется субтотальной или частичной гастрэктомией. При частичной гастрэктомии хирург сшивает небольшую часть желудка с пищеводом или тонким кишечником.
Если рак пророс в наружную стенку желудка с разрастанием в лимфатические узлы или без, можно использовать хирургическое вмешательство плюс химиотерапию или химиотерапию с радиотерапией. Хирург может выполнить субтотальную гастрэктомию или полную гастрэктомию, то есть, удаление всего желудка. При тотальной гастрэктомии хирург соединяет пищевод непосредственно с тонким кишечником.

Гастрэктомия является обширным хирургическим вмешательством, влекущим за собой неприятные последствия. После этой операции пациенту разрешается съедать только небольшое количество пищи за один раз. Распространенный побочный эффект – группа симптомов, называемых «демпинг-синдром», включающих судороги, тошноту, диарею и головокружение после еды. Это происходит, когда пища слишком быстро попадает в тонкий кишечник. Врач может предложить способы избежать симптомокомплекс и назначить лекарства для контроля над ними. Симптомы обычно уменьшаются или исчезают через несколько месяцев, но у некоторых людей они появляются постоянно. Пациентам, у которых был удален весь желудок, могут потребоваться регулярные инъекции витамина B12, так как они больше не в состоянии получать его через желудок.
Регионарные лимфоузлы часто удаляются во время операции, потому что на них может распространиться рак. Это называется лимфаденэктомия.
Это применение высокоэнергетического рентгеновского излучения или других частиц для разрушения раковых клеток. Схема терапии состоит из нескольких процедур, проводимых в течение определенного временного отрезка. Пациентам с раком желудка назначается дистанционная радиотерапия, когда излучение исходит из аппарата вне тела. Лучевая терапия может назначаться перед хирургическим вмешательством для уменьшения опухоли или после операции для уничтожения оставшихся раковых клеток.
Побочные эффекты от лучевой терапии проявляются усталостью, легкими кожными реакциями, расстройством желудка и жидким стулом. Большинство побочных эффектов исчезают вскоре после окончания лечения, но возможны и долгосрочные последствия.
Системная терапия – это введение в кровоток лекарства для уничтожения клеток злокачественной опухоли.
Обычные способы системного лечения включают установку внутривенного (ВВ) катетера в вену с помощью иглы или проглатывание (пероральный прием) таблетированной формы лекарства.
При раке желудка применяются следующие виды системной терапии:
В зависимости от ряда факторов пациенту рекомендуют как 1 вид системной терапии, так и комбинацию нескольких видов одновременно. Они также могут быть частью плана лечения, включающего хирургическую и/или радиотерапию.
Важно также сообщить врачу, принимаете ли вы другие препараты или пищевые добавки. Растительные препараты, пищевые добавки и другие лекарства взаимодействуют с противораковыми препаратами.
Химиотерапия – это применение препаратов, разрушающих опухолевые клетки, не позволяя им расти и делиться.
Режим (или схема) химиотерапии обычно состоит из нескольких циклов процедур. Проводятся они в течение некоторого временного отрезка. Одновременно пациент может получать 1 препарат или комбинацию разных препаратов.
Целью химиотерапии является разрушение раковых клеток, оставшихся после хирургического вмешательства, замедление роста клеток опухоли или снижение симптомов, связанных с раком. Ее также могут комбинировать с радиотерапией. Побочные эффекты химиотерапии зависят от индивидуальных особенностей организма, лекарственной дозировки. Могут наблюдаться утомляемость, выраженная слабость, риск инфицирования, диспепсию, облысение, снижение аппетита.

Таргетная терапия – это лечение, направленное на специфические гены, белки или тканевую среду рака, способствующую росту и выживанию рака. Таргетная терапия блокирует рост и распространение раковых клеток, одновременно ограничивая повреждение здоровых.
Не все опухоли имеют одинаковые мишени. Чтобы разработать наиболее действенное лечение, врач проводит анализы для определения генов, белков и других факторов вашей опухоли.
При лечении рака желудка применяется следующая таргетная терапия:
Иммунотерапия
Биологическая терапия (другое название) предназначена для повышения естественной защиты от рака. В ней используются вещества, вырабатываемые организмом или произведенные в лаборатории для улучшения, направления или восстановления функции иммунной системы.
Разные виды иммунотерапии могут вызывать разные негативные реакции. К общим побочным эффектам относятся кожные реакции, гриппоподобные симптомы, диарея и изменение веса.
Рак и его лечение вызывают физические симптомы и побочные эффекты, а также эмоциональные, социальные и финансовые последствия. Управление всеми этими эффектами называется паллиативной, или поддерживающей терапией. Это важная часть вашего лечения, не менее важная, чем терапия, направленная на замедление, остановку или устранения рака.
Паллиативная помощь направлена на улучшение самочувствия во время лечения путем контроля симптомов и поддержки немедицинских потребностей пациентов и их семей. Любой человек, независимо от возраста, типа и стадии рака, может получать такую помощь. Она является наиболее эффективной, если ее начать сразу же после диагностики болезни.
Паллиативное лечение очень разнообразно и часто включает медикаментозное лечение, изменение в питании, методы релаксации, эмоциональную и духовную поддержку и другие методы лечения (химиотерапия, хирургическое вмешательство или радиотерапия).
Если опухоль распространяется в другую часть тела, за пределы органа, в котором она возникла, врачи называют это метастатическим раком. У специалистов существуют разные взгляды на оптимальный стандартный план лечения. В качества варианта лечения можно также рассмотреть клинические исследования.
Целью лечения на этой стадии обычно является продление жизни пациента и устранение симптомов, так как метастатический рак желудка считается инкурабельным. Любое лечение, включая химиотерапию или лучевую терапию, считается паллиативным. Основным видом онкопомощи является химиотерапия. Важно отметить, что исследования показали, что применение паллиативной химиотерапии может улучшить и качество, и продолжительность жизни.
Это состояние, при котором в организме невозможно обнаружить рак, и его симптомы также отсутствуют.
Ремиссия бывает временной или постоянной. Эта неопределенность вызывает у многих беспокойство по поводу возможного возвращения рака. Во многих случаях ремиссия бывает временной, поэтому важно обсудить с врачом вероятность возвращения онкопроцесса. Понимание риска рецидива и возможностей лечения поможет вам чувствовать себя более подготовленными.
Если рак возвращается после первичного лечения, он называется рецидивирующим. Может повторно проявиться в том же месте (местный), рядом (регионарный) или в другом месте (отдаленный). После проведения анализов вам следует обсудить с врачом дальнейшую онкопомощь. План лечения часто включает вышеописанные виды лечения, такие как хирургическое лечение, химиотерапия и лучевая терапия, но они могут использоваться в других сочетаниях или с другой интенсивностью. Иногда, если размер рецидивирующей опухоли невелик или ее распространение ограничено, то есть, при локализованном рецидиве, вам может быть предложено хирургическое лечение.
Рак не всегда возможно вылечить. Если заболевание нельзя вылечить или контролировать, заболевание называется прогрессирующим или терминальным.
Подобный диагноз – большой стресс, и многим очень трудно обсуждать прогрессирующий рак. Важно открыто и честно разговаривать с командой медицинской помощи, объясняя свои чувства, предпочтения и страхи. Медицинская команда обладает специальными навыками, опытом и знаниями для поддержки пациентов, их семей и всегда готова прийти на помощь.
Это все то, что увеличивает вероятность развития рака у человека. И хотя факторы риска зачастую влияют на развитие заболевания, большинство из них непосредственно не вызывают онкологию. Знание своих факторов риска и обсуждение их с врачом может помочь вам сделать более осознанный выбор образа жизни и медицинского обслуживания.
Следующие факторы повышают риск развития рака:
Лечение людей, у которых диагностирован рак, не заканчивается после завершения активной терапии. Ваши врачи будут продолжать проверять, не произошел ли рецидив рака, контролировать все возможные побочные эффекты и общее состояние здоровья. Это называется последующим наблюдением. Оно включает в себя регулярные медицинские осмотры и медицинские анализы. Врачи стремятся отслеживать выздоровление в последующие месяцы и годы.
Целью последующего наблюдения является контроль рецидива. Болезнь рецидивирует из-за того, что в организме могут остаться небольшие области необнаруженных раковых клеток. Со временем эти клетки могут увеличиваться до тех пор, пока они не появятся в результатах анализов или не вызовут признаки и симптомы. Во время последующего наблюдения врач, знакомый с вашей историей болезни, может предоставить вам персональную информацию о риске рецидива. Ваш врач задаст конкретные вопросы о здоровье. Некоторым может потребоваться сдать анализы крови или пройти визуальную диагностику в рамках регулярного последующего наблюдения, но рекомендации по последующему наблюдению зависят от нескольких факторов, включая тип и стадию первоначально диагностированного рака и вид проведенного лечения.
Люди, пережившие лечение, часто удивляются, что некоторые побочные эффекты могут сохраняться после периода лечения. Это долгосрочные побочные эффекты. Другие побочные эффекты, называемые отложенными, могут развиться спустя месяцы или даже годы. К долгосрочным и отсроченным последствиям могут относиться физические и эмоциональные изменения.
Давыдов М. И. и др. Рак желудка: что определяет стандарты хирургического лечения //Практическая онкология. – 2001. – Т. 3. – №. 7. – С. 18-24.
Мерабишвили В. М. Рак желудка: эпидемиология, профилактика, оценка эффективности лечения на популяционном уровне //Практическая онкология. – 2001. – Т. 7. – №. 3. – С. 3-8.
Давыдов М. И., Тер-Ованесов М. Д. Современная стратегия хирургического лечения рака желудка //Современная онкология. – 2000. – Т. 2. – №. 1. – С. 4-10.
Бондарь Г. В. и др. Рак желудка: профилактика, диагностика и лечение на современном этапе //Онкологія. – 2006.
Давыдов М. И. и др. Рак желудка: предоперационное обследование и актуальные аспекты стадирования //Практическая онкология. – 2001. – Т. 2. – №. 3. – С. 9-17.